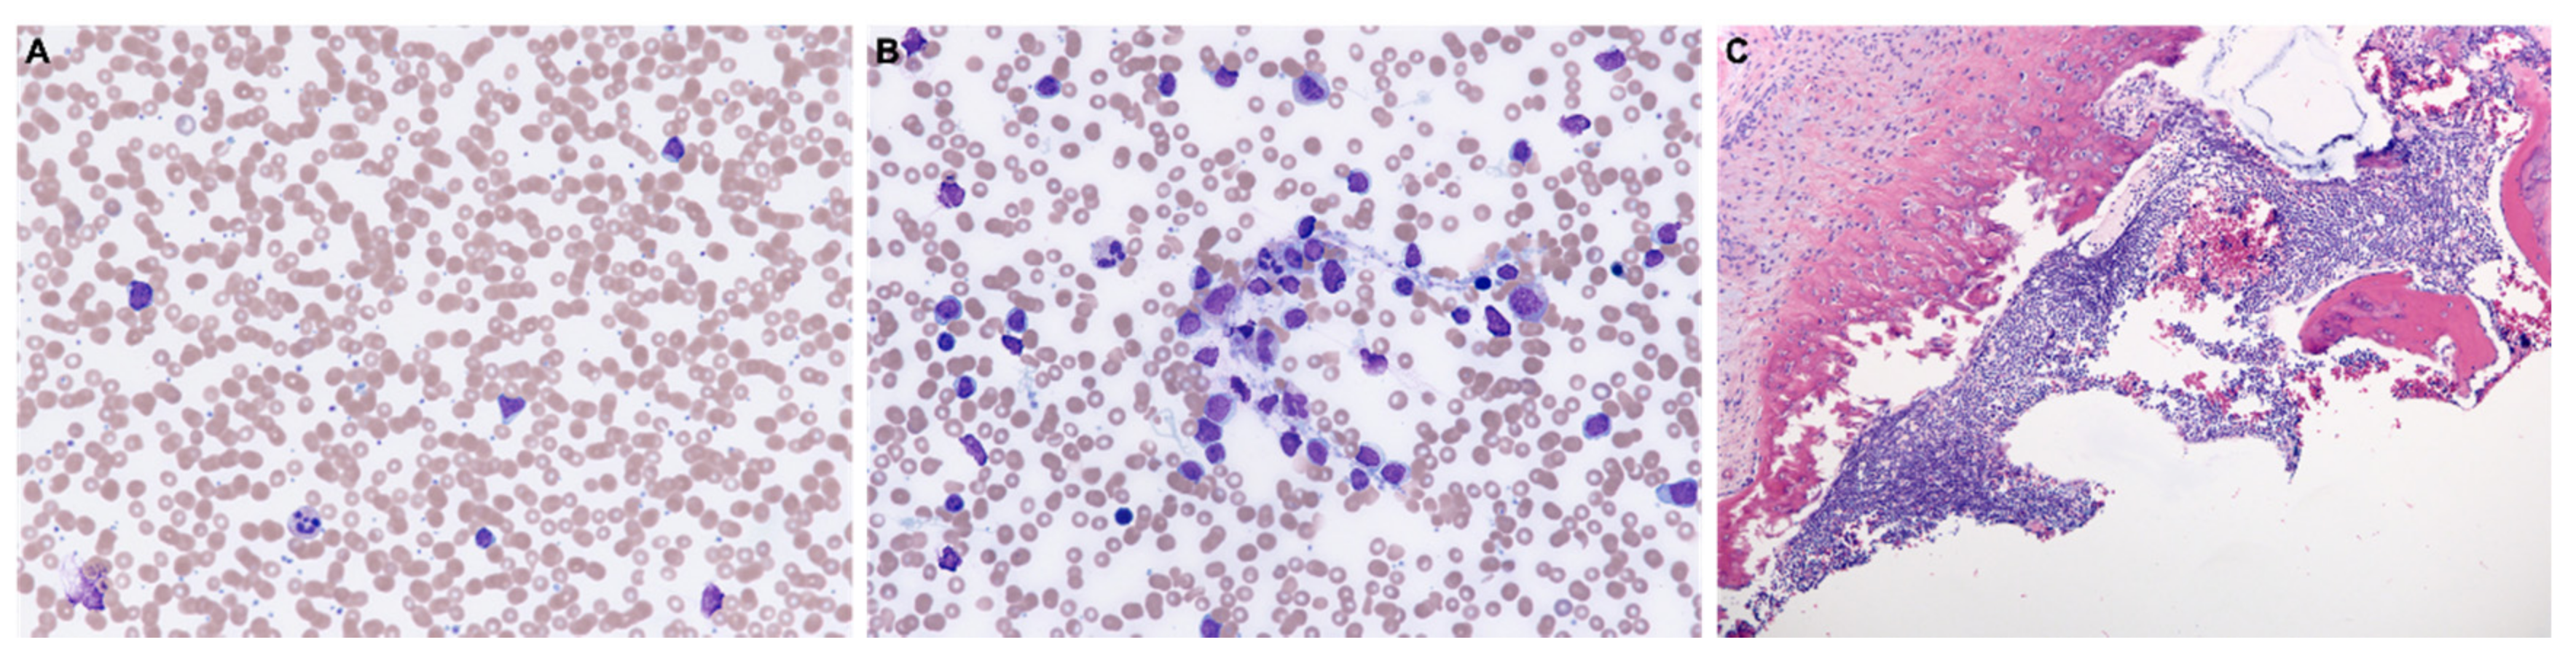
Diagnostics 11 00025 g003 Diagnostics 11 00025 g003

Hypodiploid B-Lymphoblastic Leukemia Presenting as an Isolated Orbital Mass Prior to Systemic Involvement: A Case Report and Review of the Literature
Abstract
1. Introduction
2. Case Presentation
3. Discussion
4. Conclusions
Author Contributions
Funding
Institutional Review Board Statement
Informed Consent Statement
Data Availability Statement
Acknowledgments
Conflicts of Interest
References
- Hunger, S.P.; Mullighan, C.G. Acute lymphoblastic leukemia in children. N. Engl. J. Med. 2015, 373, 1541–1552. [Google Scholar] [CrossRef] [PubMed]
- Iacobucci, I.; Mullighan, C.G. Genetic basis of acute lymphoblastic leukemia. J. Clin. Oncol. 2017, 35, 975. [Google Scholar] [CrossRef] [PubMed]
- Pui, C.-H.; Relling, M.V.; Downing, J.R. Acute lymphoblastic leukemia. N. Engl. J. Med. 2004, 350, 1535–1548. [Google Scholar] [CrossRef] [PubMed]
- Russo, V.; Scott, I.; Querques, G.; Stella, A.; Barone, A.; Delle Noci, N. Orbital and ocular manifestations of acute childhood leukemia: Clinical and statistical analysis of 180 patients. Eur. J. Ophthalmol. 2008, 18, 619–623. [Google Scholar] [CrossRef] [PubMed]
- Reddy, S.C.; Jackson, N.; Menon, B.S. Ocular involvement in leukemia—A study of 288 cases. Ophthalmologica 2003, 217, 441–445. [Google Scholar] [CrossRef] [PubMed]
- Alvarez, E.M.; Malogolowkin, M.; Hoch, J.S.; Li, Q.; Brunson, A.; Pollock, B.H.; Muffly, L.; Wun, T.; Keegan, T.H. Treatment Complications and Survival among Children and Young Adults with Acute Lymphoblastic Leukemia. JCO Oncol. Pract. 2020, 16, e1120–e1133. [Google Scholar] [CrossRef] [PubMed]
- Önder, F.; Kutluk, S.; Cosar, C.B.; Kural, G. Bilateral orbital involvement as a presenting sign in a child with acute lymphoblastic leukemia. J. Pediatr. Ophthalmol. Strabismus 2000, 37, 235–237. [Google Scholar]
- Chaudhry, S.R.; Kreis, A.J.; Underhill, H.C.; Madge, S.N. Orbital mass secondary to acute lymphoblastic leukaemia in a child: A rare presentation. Orbit 2014, 33, 421–423. [Google Scholar] [CrossRef] [PubMed]
- Goudarzipour, K.; Mohammadi, A.; Taherian, R.; Ahmadi, M.A.; Yazdi, N.A. Proptosis as Initial Presentation of Acute Lymphoblastic Leukemia in a Child with no associated symptoms: A Case Report. Iran. J. Pediatr. Hematol. Oncol. 2020. [Google Scholar] [CrossRef]
- Ramamoorthy, J.; Jain, R.; Trehan, A.; Saxena, A.K.; Ahluwalia, J. Orbital mass in a child with acute lymphoblastic leukemia: A case report and review of the literature. J. Pediatr. Hematol. Oncol. 2016, 38, 646–648. [Google Scholar] [CrossRef] [PubMed]
- Thakker, M.M.; Rubin, P.A.; Chang, E. Pre-B-cell Acute Lymphoblastic Leukemia Presenting as an Orbital Mass in an 8-Month-Old. Ophthalmology 2006, 113, 343–346. [Google Scholar] [CrossRef] [PubMed]
- Humayun, M.; Bernstein, S.L.; Gould, H.B.; Chavis, R.M. Orbital childhood acute lymphoblastic leukemia as the initial presentation. J. Pediatr. Ophthalmol. Strabismus 1992, 29, 252–254. [Google Scholar]
- Galway, N.; Johnston, R.; Cairns, C.; Thompson, A.J. Precursor B cell lymphoblastic lymphoma presenting as periorbital swelling. Case Rep. 2016. [Google Scholar] [CrossRef] [PubMed]
- Sathitsamitphong, L.; Natesirinilkul, R.; Choeyprasert, W.; Charoenkwan, P. Unusual Presentation with Orbital Mass in a Child with Precursor B-Cell Acute Lymphoblastic Leukemia. Case Rep. Hematol. 2019. [Google Scholar] [CrossRef] [PubMed]
- Bidar, M.; Wilson, M.W.; Laquis, S.J.; Wilson, T.D.; Fleming, J.C.; Wesley, R.E.; Ribeiro, R.C.; Haik, B.G. Clinical and imaging characteristics of orbital leukemic tumors. Ophthalmic Plast. Reconstr. Surg. 2007, 23, 87–93. [Google Scholar] [CrossRef] [PubMed]
- Safavi, S.; Paulsson, K. Near-haploid and low-hypodiploid acute lymphoblastic leukemia: Two distinct subtypes with consistently poor prognosis. Blood J. Am. Soc. Hematol. 2017, 129, 420–423. [Google Scholar] [CrossRef] [PubMed]

| # | Age | Sex | National Origin | Location Orbital Mass | Laterality | Presenting Signs or Symptoms | Extraorbital Disease at Presentation | Diagnostic Tests Done |
|---|---|---|---|---|---|---|---|---|
| 1 | 21mo | M | Iran | Superolateral | L | Proptosis, tenderness, and tearing | Bilateral submandibular lymphadenopathy; abnormal CBC | Bone marrow aspiration |
| 2 | 3yrs | M | UK | Superior | L | Intermittent lid swelling; mild proptosis and hypoglobus; fatigue, fever, and weight loss. | Multiple lymph nodes; abnormal CBC | Peripheral blood smear and the bone marrow biopsy |
| 3 | 4yrs | F | India | Superomedial | L | Fevers, bone pain, and proptosis | Generalized lymphadenopathy; hepatosplenomegaly; abnormal CBC | Peripheral blood smear and the bone marrow biopsy; multiplex polymerase chain reactions for t(9;22), t(4;11), t(12;21), and t(1;19) |
| 4 | 8mo | F | USA | Superior | R | Eyelid swelling and epiphora | Cervical lymph node | Biopsy of the cervical lymph node; bone marrow biopsy; cytogenetic analysis |
| 5 | 18mo | M | USA | Nasal | L | Ptosis, proptosis, and extropia | Abnormal CBC | Orbital mass biopsy |
| 6 | 11yrs | F | UK | Lateral | B | Headache; weight loss; painful groin swelling | Inguinal lymphadenopathy | Bone marrow aspiration and trephine; cytogenetics and flow cytometry; biopsy of inguinal node; lumbar puncture |
| 7 | 3yrs | F | Thailand | Lateral | R | Proptosis; ocular motility deficits | Hepatosplenomegaly; abnormal CBC | Bone marrow aspiration; immunophenotype analysis by flow cytometry; bone marrow cytogenetic study |
| 8 | 4yrs | M | USA | Superior | R | Eyelid swelling; hypoglobus; ocular motility deficit | None | Orbital mass biopsy; peripheral blood smears; bone marrow aspirate smears; flow cytometry; UCSF500 molecular test (next generation sequencing) |
Publisher’s Note: MDPI stays neutral with regard to jurisdictional claims in published maps and institutional affiliations. |
© 2020 by the authors. Licensee MDPI, Basel, Switzerland. This article is an open access article distributed under the terms and conditions of the Creative Commons Attribution (CC BY) license (http://creativecommons.org/licenses/by/4.0/).
Share and Cite
Wang, L.; Ashraf, D.C.; Kinde, B.; Ohgami, R.S.; Kumar, J.; Kersten, R.C. Hypodiploid B-Lymphoblastic Leukemia Presenting as an Isolated Orbital Mass Prior to Systemic Involvement: A Case Report and Review of the Literature. Diagnostics 2021, 11, 25. https://doi.org/10.3390/diagnostics11010025
Wang L, Ashraf DC, Kinde B, Ohgami RS, Kumar J, Kersten RC. Hypodiploid B-Lymphoblastic Leukemia Presenting as an Isolated Orbital Mass Prior to Systemic Involvement: A Case Report and Review of the Literature. Diagnostics. 2021; 11(1):25. https://doi.org/10.3390/diagnostics11010025
Chicago/Turabian StyleWang, Linyan, Davin C. Ashraf, Benyam Kinde, Robert S. Ohgami, Jyoti Kumar, and Robert C. Kersten. 2021. "Hypodiploid B-Lymphoblastic Leukemia Presenting as an Isolated Orbital Mass Prior to Systemic Involvement: A Case Report and Review of the Literature" Diagnostics 11, no. 1: 25. https://doi.org/10.3390/diagnostics11010025
APA StyleWang, L., Ashraf, D. C., Kinde, B., Ohgami, R. S., Kumar, J., & Kersten, R. C. (2021). Hypodiploid B-Lymphoblastic Leukemia Presenting as an Isolated Orbital Mass Prior to Systemic Involvement: A Case Report and Review of the Literature. Diagnostics, 11(1), 25. https://doi.org/10.3390/diagnostics11010025

